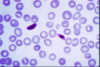

CÉLULAS EM LÁGRIMA OU DACRIÓCTIOS (…)
EM PACIENTES COM ESPLENOMEGALIA —> MIELOFIBROSE IDIOPÁTICA

AUMENTO DO BAÇO
POSSÍVEL AUMENTO DO FÍGADO
ESTÔMAGO CHEIO DE CONTEÚDO.

CINITOLOGRAFIA ESPLÊNICA
1.VERIFICAR HIPERESPLENISMO OU BAÇO ECTÓPICO

ENUNCIADO DEMOSTRA FRATURA PÉLVICA , COM DESLOCAMENTO DA PRÓSTATA AO TOQUE.
1.CONDUTA –> FIXAÇÃO EXTERNA DA PELVE .
O EXAME DEMONSTRADO É :
1.URETROCISTOGRAFIA RETRÓGRADA ( CONSIDERAR CONTEXTO DO TRAUMA )
2.DEMONSTRA LESÃO DE URETRA .
LEMBRANDO QUE NESSE CASO , NÃO PODEMOS FAZER CATETERIZAÇÃO VESICAL .
* SE A URETROCISTOGRAFIA ESTIVESSE NORMAL DEVERÍAMOS REALIZAR CISTOGRAFIA.

PRESENÇAÇ DE VIA BILIAR DILATA + CALCULO DENTRO DA VESICULA .
O EXAME DE IMAGEM É : CPRE ( NOTE A PRESENÇA DE CONSTRASTE )

CONJUNTIVITE –> CLÁSSICA DA DOENÇA DE KAWASAKI

EDEMA DE MÃO CLÁSSICA DA DOENÇA DE KAWASAKI

LESÃO DE ENDOMETRIOSE

LESÃO DE ENDOMETRIOSE

LESÃO DE ENDOMETRIOSE

PRESENÇA DE AR NA VESICULA BILIAR.

IMAGEM COM SOMBRA ACUSTICA POSTERIOR.
DIAGNÓSTICO DE COLELÍTIASE. PODENDO OU NÃO HAVER COLECISTITE DEPENDENDO DA CLÍNICA DA PACIENTE.

TOMOGRAFIA DE ABDOMEN COM CONSTRASTE VENOSO .
MASSA RETROPERITONEAL A DIREITA QUE COMPRIME AS VISCERAS A DIREITA , A QUAL NÃO INVADE AS ESTRUTURAS. PRESENÇA DE CAPTAÇÃO HETEROGENEA DO CONSTRASTE NA PERIFERIA
ASPECTO DE SARCOMA PERITONEAL.

NÓDULO SOLITÁRIO
MELHOR MODO DE VERIFICIAR MALIGINIDADE É VER O CRESCIMENTO NOS ULTIMOS DOIS ANOS
PRESENÇA DE LESÃO PERIFÉRICA, AQUAL , É REALIZADA BX COM VIDEOTORACOSCOPIA.

TOMOGRAFIA COM PRESENÇA DE LESÃO CAVITÁRIA EM PULMAO ESQUERDO
1.CÂNCER ?
- *2.TUBERCULOSE
3. ABSCESSO ?**
4.LESÃO FUNGICA ?

PROVA DE PREVENTIVA , CIRCULO FAMILIAR

PRESENÇA DE LESÃO À NÍVEL DE COLON TRANSVERSO. POIS O CONSTRASTE NÃO PASSA NO NÍVEL DO CÓLON TRANSVERSO . JÁ NO CÓLON ESQUERDO VOCÊ NOTA A PRESENÇA DO CONTRASTE.

LESÃO QUE COMPRIME ESTRUTURAS ADJACENTES.
CONFIGURANDO COMO LINFOMA DE HO…LINFOMA DE TIREÓIDE OCORRE UM CRESCIMENTO MAIS RÁPIDO.

1. VEIA MESENTÉRICA
2.ARTÉRIA MESENTÉRICA
3. VEIA RENAL.

bismutti do tipo 2a

esofago normal.

dilatacao do corpo esofagiano.

acalasia , com contração do esofago.

espasmos esofagiano difuso , esofago em saca rolhas.